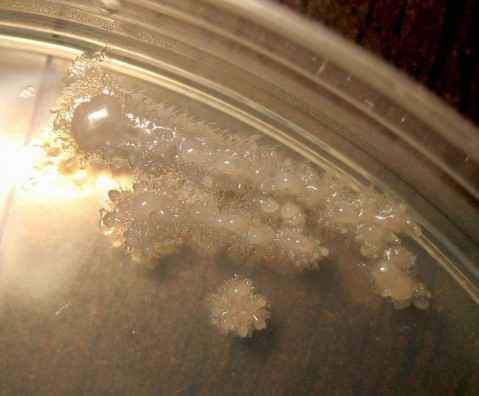
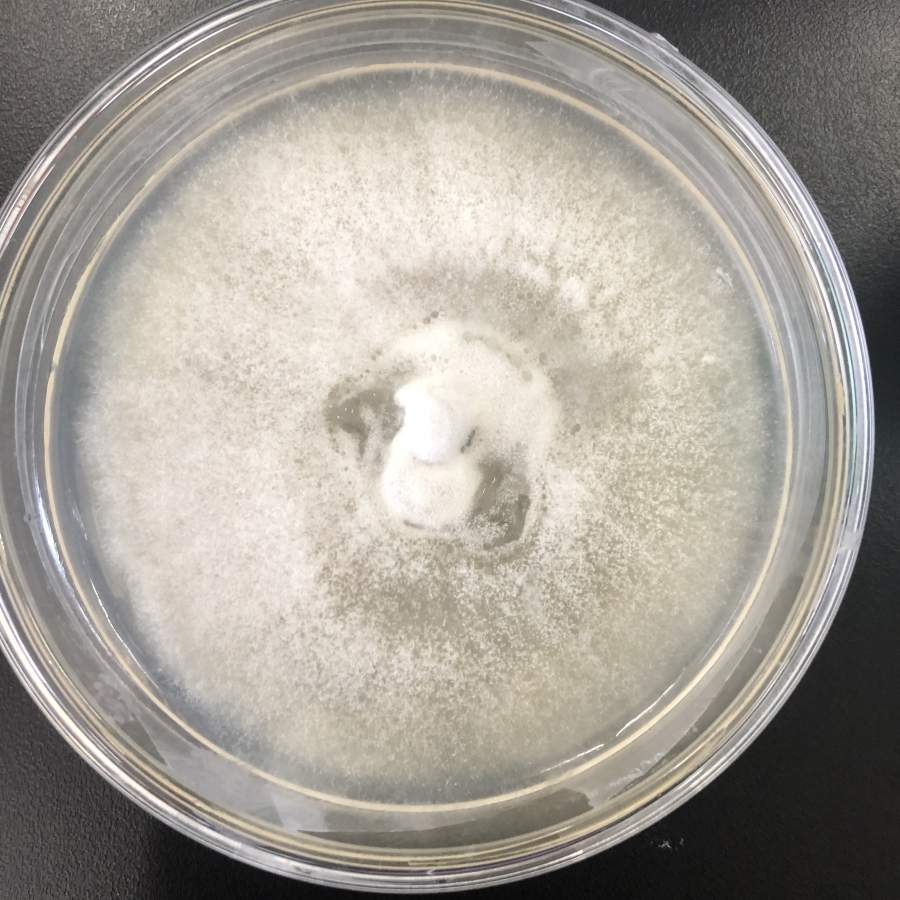

中南大学湘雅口腔医学院微生物方向科研助理招聘【申请表格见链接】
missjia2005
中南大学湘雅口腔医学院陈晓婧教授团队依托口腔健康研究湖南省重点实验平台,致力于口腔材料学方面研究,主要关注生物活性玻璃材料在口腔临床应用中的基础研究及产业化转化。现因科研需求,面向全社会公开招聘非事业编制科研助理。招聘事宜公告如下:'http://rsc.cs...
微生物
- 400
- 8
关于涂布平板计数法的疑惑
houzhaoqian
在使用涂布法进行平板计数操作的时候,如果涂布1mL、0.5mL、0.1mL,平板上的菌落数会不会有差异,不同的接种量,最后获得的结果都是CFU/mL吗?还是CFU/0.5mL或者CFU/0.1,mL。请各位大神解惑。
微生物
- 350
- 7

京公网安备 11010802022153号
京公网安备 11010802022153号